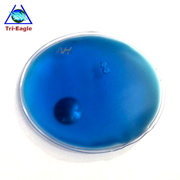
name

科诺拉纺车轮金属渔轮渔线轮海杆轮鱼线轮锚鱼轮远投轮鱼轮渔具|ms
Price: US.$36.7
海钓适用纺车轮全金属7+1BB浅线杯路亚渔线轮跨境厂家专供批发|ms
Price: US.$115.9
长款项链韩国时尚高亮珍珠装饰链气质百搭毛衣链挂件厂家批发挂饰|ms
Price: US.$106.98
水木JBK跨境无间隙纺车轮精雕铝合金浅线杯鱼线轮 新款路亚渔轮|ms
Price: US.$42.2
金鲨王碳素纺车轮高端渔轮微物路亚双轴承纺车轮远投轮纺车轮|ms
Price: US.$95.1
惠钓无间隙顺滑纺车轮全金属斜口线杯远投微物泛用正品路亚海钓轮|ms
Price: US.$59.29
金属渔轮路亚纺车轮 金属浅线杯渔轮 微物鱼轮 渔线轮渔具批发新|ms
Price: US.$62.41
小斯泰拉纺车轮不锈钢轴承防水轻量化碳素摇臂泛用路亚正海钓轮AP|ms
Price: US.$63.89
启程GLB雷纹路亚纺车轮微物打黑海钓远投鱼轮金属脚线杯渔轮批发|ms
Price: US.$57.95
金属渔轮路亚纺车轮 金属浅线杯渔轮 微物鱼轮 渔线轮渔具批发新|ms
Price: US.$74.89
小斯泰拉纺车轮不锈钢轴承防水轻量化碳素摇臂泛用路亚正海钓轮AP|ms
Price: US.$76.67
跨境供应 理发师发型师剪发梳子黑色苹果梳双面男发女发平头尖尾|ms
Price: US.$5.35
【今日福利】鱼子酱修复发膜1000ml 修复受损发质 柔顺头发|ms
Price: US.$17.12
摩托车电动车改装配件跨境热销款 改装CNC手把把套铝合金手把胶|ms
Price: US.$9.66
加厚快递自粘袋电商快递袋现货打包袋快递防水袋跨境大批量包装袋|ms
Price: US.$7.47
世界杯足球opp平口袋糖果饼干玻璃纸扎口袋精美包装袋厂家跨境|ms
Price: US.$5.91
粉色蝴蝶结手提礼品袋儿童生日派对零食包装塑料珠光回礼袋糖果袋|ms
Price: US.$20.8
ins风卡通星星小猫线条狗OPP印花自粘袋小卡片自封袋拍立得打包袋|ms
Price: US.$34.77
蝴蝶结礼袋儿童卡通生日主题派对手提回礼袋珠光膜礼品袋礼物包装|ms
Price: US.$5.94
文艺小清新袋子饰品袋子可爱卡通塑料袋礼品袋服装袋子批发包邮|ms
Price: US.$7.43
跨境蝴蝶结礼物糖果袋玻璃纸礼品袋印花饼干包装袋opp平口袋批发|ms
Price: US.$5.19
礼品手提袋跨境粉色蝴蝶结系列印花塑料平口手提袋珠光膜饰品袋|ms
Price: US.$11.89
足球图案opp平口袋运动系列小清新礼品袋橄榄球礼物包装 袋批发|ms
Price: US.$5.19
跨境卡通赛车主题印花纸袋节日糖果包装袋派对礼品袋平 OPP包装袋|ms
Price: US.$10.37
龙女字母印花托特包女大容量手提单肩包通勤百搭尼龙斜挎包|ms
Price: US.$9.66
【跨境】J 高尔夫腰带男女 运动潮流柔软Golf皮带可调节#2501|ms
Price: US.$14.86
1:1 designer bags high quality luxury famous brands handbags|ms
Price: US.$132.99
Customer order designer handbags大牌包包 品牌女包 高档名牌包|ms
Price: US.$111.44
红带干胶发胶特硬定型清香香味奢华干胶男士强力蓬松喷雾发蜡发泥|ms
Price: US.$513.52
海钓适用纺车轮全金属7+1BB浅线杯路亚渔线轮跨境厂家专供批发|ms
Price: US.$115.9
风火轮速度与激情HNR88霓虹飞车复古赛车俱乐部达HDG52 JBY68|ms
Price: US.$8.32
2025K风火轮C4982小跑车法拉利F40迈凯伦福特野马阿尔法25K小车|ms
Price: US.$2.67
2025A火辣小跑车Q版尼桑天际线本GTR本田思域EF合金小车25A|ms
Price: US.$6.69
跨境S25 Ultra+安卓16+512G大屏手机源头厂家Smart Phone(劲爆款)|ms
Price: US.$69.84
- 1
- 2
- 3
- 4
- 5
- 6
- 223